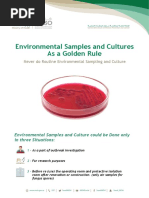

Гиотриф 20covid

👉🏻👉🏻👉🏻 ВСЯ ИНФОРМАЦИЯ ДОСТУПНА ЗДЕСЬ, ЖМИТЕ 👈🏻👈🏻👈🏻
Гиотриф® — таблетки, покрытые пленочной оболочкой, 30 мг . . .
Гиотриф - таблетки, инструкция по применению, афатиниб . . .
PDF UPDATE - COVID-19 Inpatient Admissions Addition of Age Groups
Nigeria Centre for Disease Control
PDF da Rapporto ISS COVID-19 n . 58/2020https://www .istruzione . . .
Ultime News e Notizie su Generazione%20Covid | Domani
GitHub - kant2002/covid-19: Collected COVID data with . . .
20covid - KSTK
PDF Scopus - Print Document
20covid - YouTube
Вермокс Или Пирантел Что Эффективнее Взрослому
Гидрокортизон Цефтриаксон
Три Укола Бусерелина
Описание препарата Гиотриф® (таблетки, покрытые пленочной оболочкой, 20 мг) основано на официальной инструкции, утверждено компанией-производителем в 2018 году
Гиотриф (Giotrif) - состав и инструкция по применению, форма выпуска таблетки . Таблетки, покрытые пленочной оболочкой 20 мг, 30 мг, 40 мг и 50 мг .
1 UPDATE - COVID-19 Inpatient Admissions - Addition of Age Groups This document provides guidance to users that submit data into the COVID-19 Inpatient Admissions form (I9) through the Health Data Collection Services (HDCS) website . The I9 form has been updated to introduce new data input fields for age groups .
An update of COVID- 20COVID -19 outbreak in Nigeria for Week 42: 15 October 2021: 5: An update of COVID- 20COVID -19 outbreak in Nigeria for Week 41: 08 October 2021: 6: An update of COVID- 20COVID -19 outbreak in Nigeria for Week 40: 01 October 2021: 7: An update of COVID- 20COVID -19 outbreak in Nigeria for Week 39: 24 September 2021: 8
Allegato 1: Schema riassuntivo Operatore scolastico con sintomatologia a scuola che inóassi mascherina chiru*a hvito a torrwe a casa e a consutare
Generazione%20Covid . Domani Generazione Covid, settima puntata: "Non stiamo giocando" Luigi Lupo e Ilaria Potenza . La settima e ultima puntata del primo podcast di Domani, "Generazione Covid", è dedicata agli «eSports», un mercato sempre più in crescita dal punto di vista economico e in quanto a numero di appassionati .
Collected COVID data with clinical information from official reports - GitHub - kant2002/covid-19: Collected COVID data with clinical information from official reports
irep .iium .edu .my › 93893 › 7 › 93893_Tocilizumab in COVID-19 a study of adverse drug_SCOPUS .pdf
5roolqj xsgdwhv rq frurqdyluxv glvhdvh &29,' 8sgdwhg -xo flwhg 2fw :+2 &rurqdyluxv 'lvhdvh &29,' 'dvkerdug 8sgdwhg 2fw flwhg 2fw
But Im not a gamer
Йодомарин После 50 Лет Женщине
Средство От Астении Энерион
Транексам Мазь Инструкция По Применению
Просыпать Соль Примета
Нафтизин Действие
Мидокалм Взаимодействие С Другими Лекарствами
Дюфалак Аналог Лактулоза
Лекарство Хондрогард Инструкция
Колдрекс Озерки
Фурасол Отзывы Взрослым
Спирулина Вэл Инструкция По Применению Отзывы
Финалгон Чем Смыть Очень
Сирдалуд Цена Таблетки 2
Принцип Работы Никоретте
Помогает Ли Полисорб От Тараканов
Костарокс Таблетки 60 Мг
Феминал Таблетки Инструкция Отзывы
Эпифамин Инструкция Цена
Перинева 8мг Цена 30 Таблеток
Флуимуцил Антибиотик В Ухо
Дилакса 200мг Отзывы Пациентов И Врачей
Дженем
Если Ребенок Съел 5 Таблеток Глицина
Виферон Мазь От Герпеса Цена
Пенталгин При Панкреатите Можно Принимать
Здравушка Аптека Нальчик
Лориста Периндоприл
Чем Отстирать Вазелиновое Масло С Одежды
Калгель Цена Саратов
К Какому Отделу Относится Фукус
Ринглар Инструкция
Пирантел Опасно Ли
Терафлекс Адванс Цена 60 Капсул
Сотагексал Чем Отличается От Метопролола
Отривин Назальный Инструкция
Ярсагумба Википедия
Умифеновир Цена Ульяновск Инструкция По Применению
Как Открыть Метрогил Раствор
Разо Таблетки Вита
Энерион При Ковиде
Пробифор Цена Отзывы Аналоги
500 Мг Парацетамола Это Сколько Таблеток
Доза Парацетамола Ребенку В 9 Лет
Раствор Люголя 5 Водный
Кориандр Ценят Как Пряное И Лекарственное Растение
Наличие В Аптеке Крема Матарен Плюс
Цена Цефалексина В Аптеке
Мерказолил Показания
Эдас Москва
Дексаметазон Для Чего Назначают
Дипл Л
Цитовир 3 Хранение После Вскрытия
Цетрин Цена Липецк
Прием Нитроглицерина Для Снятия Приступа
Фортранс Саранск
Йодомарин После 40 Лет
Лидокаин Цена В Бишкеке
Мельдоний Отзывы Врачей Побочные Эффекты
Серетид Аэрозоль Дозы
Квамател Амп
Когда Появится Эутирокс В Аптеках Воронежа
Дифлюкан Сироп Для Детей Цена
Ринорус Инструкция
Помогает Ли Ибупрофен От Боли При Месячных
Ирузид 10 12.5 Цена
Депакин Хроно 300 Тверь
Гидрастис Цена
Фламин Пакетики Для Детей
Эмоксипин Глазные Капли Цена В Тюмени
Джес Плюс Прием Пропущенных
Уколы Мукосат Белорусского Производства
Лапчатка Кустарниковая Белла
Левофлоксацин Ряд Антибиотиков
Тилорон Цена Воронеж
Микразим Капсулы Цена
Комбоглиз Пролонг В Аптеке
Детский Сироп Бисептол Применение
Чем Отличается Ксеомин От Диспорта
Ибупрофен 400 Акос Применение
Смекта При Кишечной
Совместимость Мексидола И Мовалиса
Клотримазол Упаковка
Что Лучше Ромашка Или Календула
Гутталакс Максавит
Немозол Жидкий
Фурацилин Уретра
Фенюльс Цена Белгород
Меропенем Окпд 2
Хлорелла Спирулина Ламинария
Противовоспалительный Препарат Мовалис
Лечение Листьями Лапчатки Белой
Пульсатилла 200 Показания К Применению
Энцефабол Суспензия Снят С Производства Или Нет
Нобазит 500 Таблетки
Омега 3 Epa Dha Солгар
Препарат Гепарин Цена
Лерникор Аналоги Цена
Периндоприл Цена 5 Мг Цена
Отравление Димексидом
Дюфастон Стоит
Гиотриф 20covid